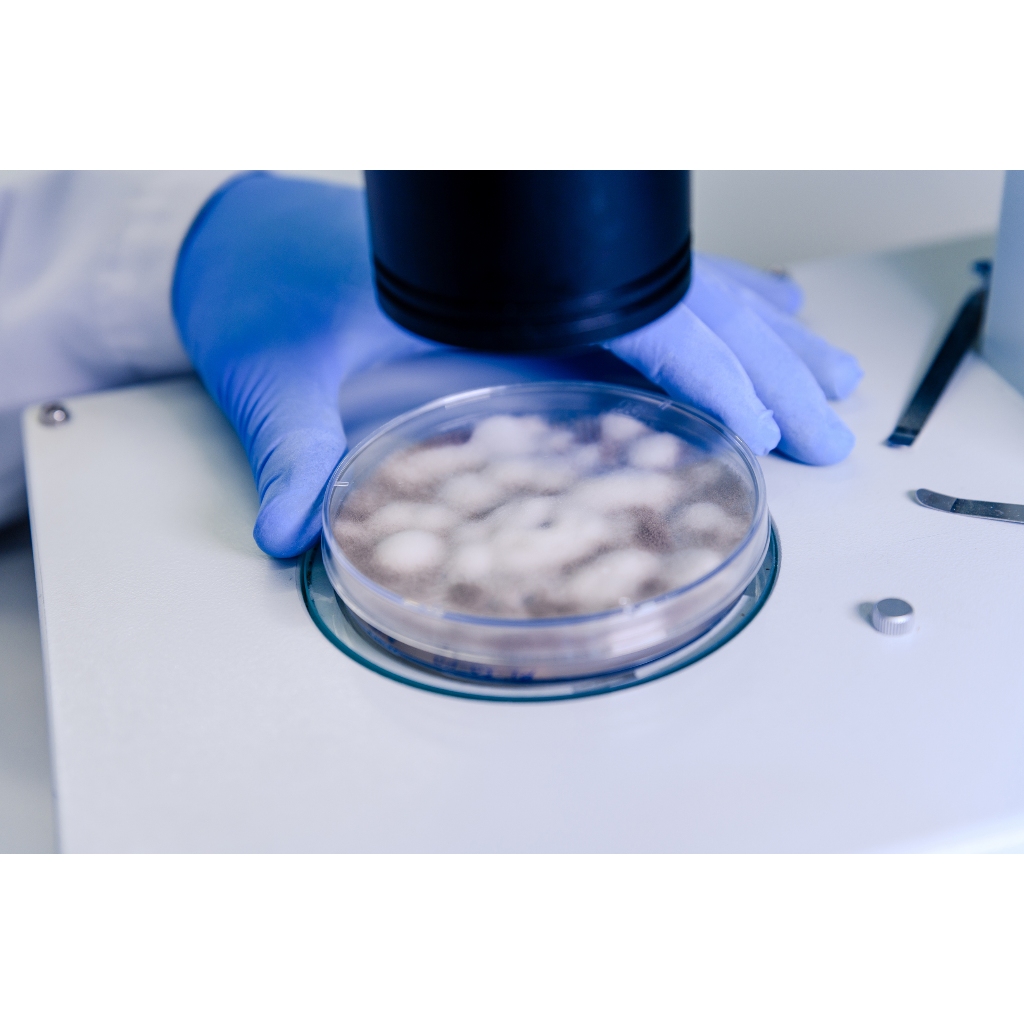

1/12
2 phân loại có sẵn
ATP Farm : CMP - THA Bào tử vi sinh Trichoderma harzianum nấm đối kháng quan trọng nông nghiệp sinh học Hủ 100g - 300g
Nhận từ 8 Th04 - 11 Th04
Phí ship 0₫
Tặng Voucher 15.000₫ nếu đơn giao sau thời gian trên.
Trả hàng miễn phí 15 ngày